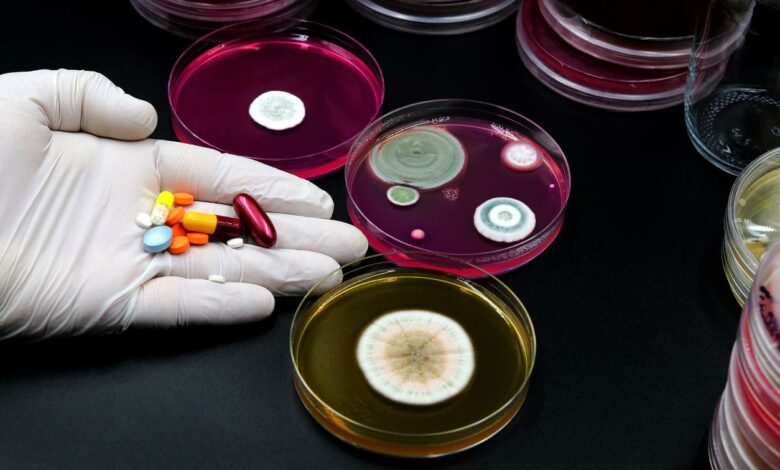

La résistance aux antibiotiques est l’une des plus graves menaces pesant sur la santé mondiale. Une récente étude met en évidence les facteurs influençant cette résistance et les différentes tendances observées.
- Il n’existe pas une résistance aux antibiotiques mais plusieurs, très dépendantes des espèces bactériennes.
- En 2019, 1,27 millions de décès dans le monde résultaient de la résistance aux antibiotiques et 4,95 millions y étaient associés.
- Les stratégies de lutte contre la résistance aux antibiotiques à l’échelle mondiale doivent être adaptées en tenant compte des espèces, de la résistance et des contextes épidémiologiques en jeu.
L’antibiorésistance est un phénomène naturel mais le mauvais usage des antibiotiques y contribue en sélectionnant les résistances et en complexifiant la lutte contre les infections bactériennes.
Des scientifiques de l’institut Pasteur, l’INSERM et des universités de Versailles Saint-Quentin-en-Yvelines et de Paris-Saclay ont estimé qu’en 2019, 1,27 millions de décès dans le monde résultaient de la résistance aux antibiotiques et 4,95 millions y étaient associés. Ces chiffres mettent en évidence l’urgence d’agir afin de préserver l’efficacité des antibiotiques.
Des facteurs influençant la résistance
Au total, 11 facteurs ont été retenus, notamment la qualité du système de soins, la consommation d’antibiotiques et la richesse du pays, ainsi que des données sur les voyages et des variables climatiques. Il est intéressant de noter que la bonne qualité du système de santé d’un pays est associée à de faibles niveaux d’antibiorésistance chez toutes les bactéries à Gram négatif testées. Cela souligne l’importance d’investir dans des systèmes de santé solides et accessibles pour lutter contre ce fléau grandissant.
De plus, les températures élevées sont, elles, associées à des forts niveaux d’antibiorésistance mais uniquement chez les Entérobactéries. Ces facteurs sont essentiels à prendre en compte dans l’élaboration de stratégies de lutte.






